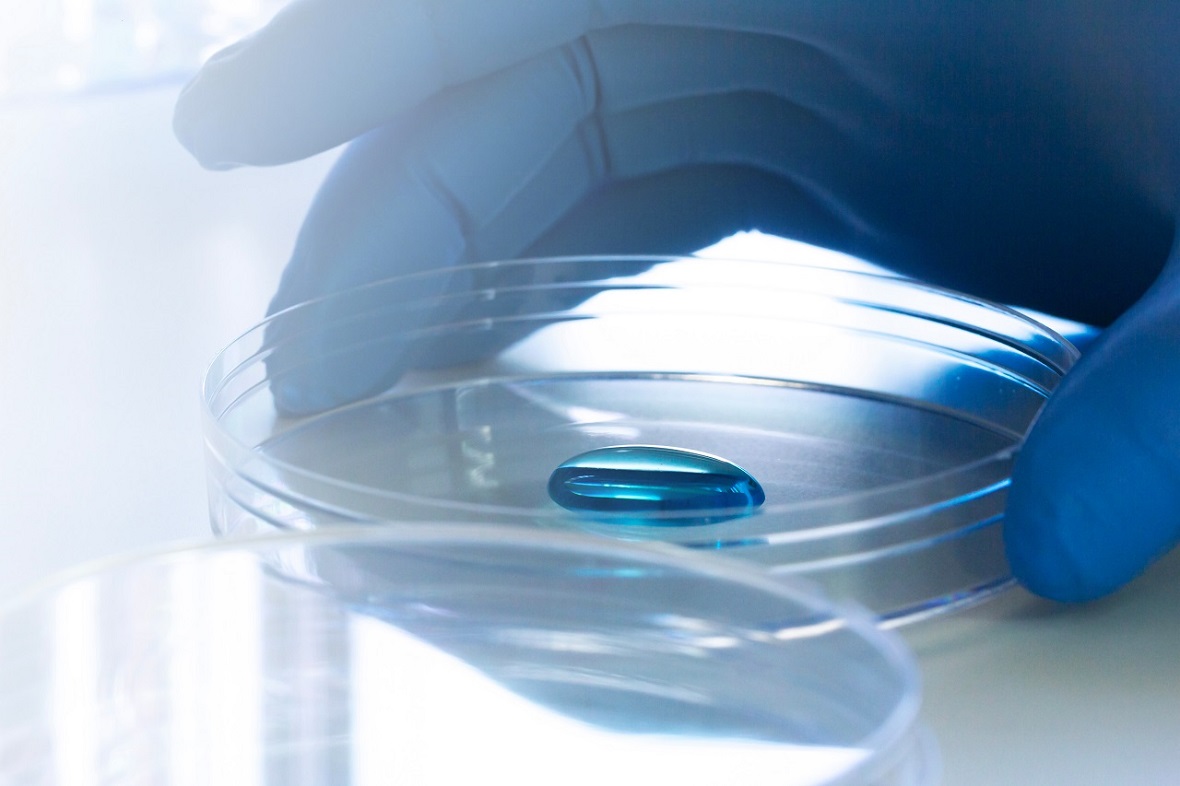
ivdr6

Ecco perchè Kiwa, attraverso le sue società di formazione, offre una gamma completa di corsi di formazione sui dispositivi medici realizzati in linea con le strategie aziendali e le trasformazioni sociali del settore sanitario e della produzione e commercializzazione dei dispositivi medici.
Per questi settori, la formazione è strutturata in modo tempestivo ed efficace grazie all'esperienza acquisita da Kiwa negli anni nella certificazione di sistema e di prodotto, nell'innovazione e nel supporto all'accreditamento professionale e istituzionale.